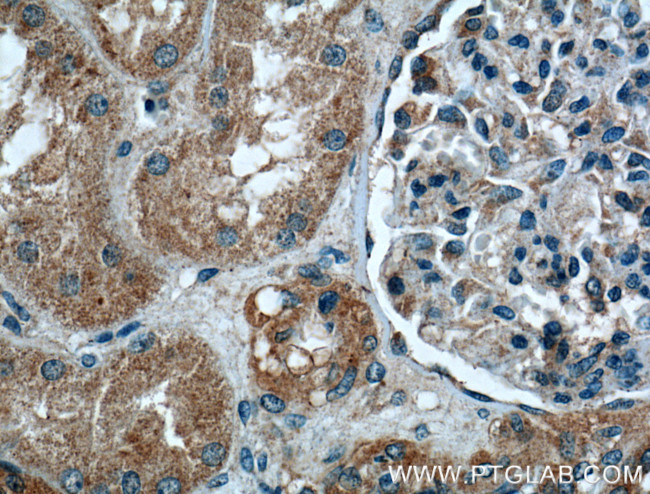
Integrin alpha-6 Antibody in Immunohistochemistry (Paraffin) (IHC (P))

Search
Proteintech
Integrin alpha-6 Polyclonal Antibody
{{$productOrderCtrl.translations['antibody.pdp.commerceCard.promotion.promotions']}}
{{$productOrderCtrl.translations['antibody.pdp.commerceCard.promotion.viewpromo']}}
{{$productOrderCtrl.translations['antibody.pdp.commerceCard.promotion.promocode']}}: {{promo.promoCode}} {{promo.promoTitle}} {{promo.promoDescription}}. {{$productOrderCtrl.translations['antibody.pdp.commerceCard.promotion.learnmore']}}
产品信息
27189-1-AP
种属反应
已发表种属
宿主/亚型
分类
类型
抗原
偶联物
形式
浓度
规格
纯化类型
保存液
内含物
保存条件
运输条件
产品详细信息
Immunogen sequence: TPNRIDLRQ KTACGAPSGI CLQVKSCFEY TANPAGYNPS ISIVGTLEAE KERRKSGLSS RVQFRNQGSE PKYTQELTLK RQKQKVCMEE TLWLQDNIRD KLRPIPITAS VEIQEPSSRR RVNSLPEVLP ILNSDEPKTA HIDVHFLKEG CGDDNVCNSN LKLEYKFCTR EGNQDKFSYL PIQKGVPELV LKDQKDIALE ITVTNSPSNP RNPTK (477-690 aa encoded by BC136456)
靶标信息
CDf (Integrin alpha-6, ITGA6) is the integrin alpha chain alpha 6 protein. Integrins are integral cell-surface proteins composed of an alpha chain and a beta chain. A given chain may combine with multiple partners resulting in different integrins. For example, alpha 6 may combine with beta 4 in the integrin referred to as TSP180, or with beta 1 in the integrin VLA-6. Integrins are known to participate in cell adhesion as well as cell-surface mediated signaling. Two transcript variants encoding different isoforms have been found for CDf. Functionally, integrins are cell surface receptors that interact with the extracellular matrix and mediate intracellular signals that affect cellular shape, mobility, and progression through the cell cycle in response to the extracellular matrix. Integrin receptors are composed of alpha and beta subunits, and form structural and functional linkages between the ECM (extra-cellular matrix) and intracellular cytoskeletal linker proteins. Signaling mediated by Intergrin/ECM interactions are also integrated with cellular responses to growth factor signaling to regulate cellular proliferation, cytoskeletal reorganization and other responses necessary for cellular survival. CDf is predominantly expressed by epithelia, and plays a critical structural role in the hemidesmosome. More than 18 alpha and 8 beta subunits with numerous splice variant isoforms have been identified in mammals. Certain integrins can also bind to soluble ligands or to counter-receptors on adjacent cells, such as the intracellular adhesion molecules (ICAMs), resulting in aggregation of cells.
仅用于科研。不用于诊断过程。未经明确授权不得转售。
生物信息学
蛋白别名: CD49 antigen-like family member F; CD49f; DKFZp686J01244; extracellular matrix receptor subunit; FLJ18737; Integrin alpha-6; integrin alpha6B; integrin, alpha 6; unnamed protein product; very late activation protein 6; VLA-6
基因别名: 5033401O05Rik; AI115430; CD49f; ITGA6; ITGA6A; ITGA6B; JEB6; VLA-6
UniProt ID: (Human) P23229, (Mouse) Q61739
Entrez Gene ID: (Human) 3655, (Rat) 114517, (Mouse) 16403